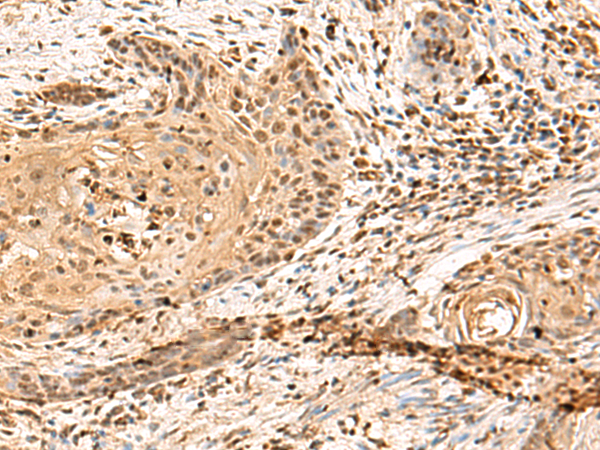

中文名稱: 兔抗PTH1R多克隆抗體
英文名稱: Anti-PTH1R rabbit polyclonal antibody
別 名: parathyroid hormone 1 receptor; PFE; PTHR; PTHR1
相關類別: 一抗
儲 存: 冷凍(-20℃)
宿 主: Rabbit
抗 原: PTH1R
反應種屬: Human, Mouse, Rat
標 記 物: Unconjugate
克隆類型: rabbit polyclonal
技術規格
|
Background: |
The protein encoded by this gene is a member of the G-protein coupled receptor family 2. This protein is a receptor for parathyroid hormone (PTH) and for parathyroid hormone-like hormone (PTHLH). The activity of this receptor is mediated by G proteins which activate adenylyl cyclase and also a phosphatidylinositol-calcium second messenger system. Defects in this receptor are known to be the cause of Jansen's metaphyseal chondrodysplasia (JMC), chondrodysplasia Blomstrand type (BOCD), as well as enchodromatosis. Two transcript variants encoding the same protein have been found for this gene. |
|
Applications: |
ELISA, IHC |
|
Name of antibody: |
PTH1R |
|
Immunogen: |
Fusion protein of human PTH1R |
|
Full name: |
parathyroid hormone 1 receptor |
|
Synonyms: |
PFE; PTHR; PTHR1 |
|
SwissProt: |
Q03431 |
|
ELISA Recommended dilution: |
5000-10000 |
|
IHC positive control: |
Human tonsil and Human esophagus cancer |
|
IHC Recommend dilution: |
50-300 |

購物車
幫助
021-54845833/15800441009
